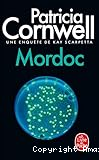

BibliothÃĻque Michery
 Accueil
Accueil
DÃĐtail de l'auteur
Auteur HÃĐlÃĻne Narbonne (1957-....) |
Documents disponibles écrits par cet auteur


 Affiner la recherche
Affiner la recherche
texte imprimÃĐ
Patricia Cornwell, Auteur ; HÃĐlÃĻne Narbonne, Traducteur | Paris : Librairie gÃĐnÃĐrale française | Le livre de poche | 2001Un cadavre dÃĐcomposÃĐ est retrouvÃĐ Ã bord d'un cargo belge faisant ÃĐtape à Richmond. MalgrÃĐ une autopsie minutieuse, Kay Scarpetta ne parvient à dÃĐterminer ni l'identitÃĐ du mort ni les causes du dÃĐcÃĻs. Seuls indices : un tatouage et des poils blo[...]
texte imprimÃĐ
Patricia Cornwell, Auteur ; HÃĐlÃĻne Narbonne, Traducteur | Paris : Librairie gÃĐnÃĐrale française | Le livre de poche | 2002K ay Scarpetta se remet à peine de l'attaque d'un monstrueux serial killer , Jean-Baptiste Chandonne. Le tueur vient d'Être arrÊtÃĐ, mais le cauchemar n'est pas terminÃĐ pour autant. Car, de victime, Kay risque de se retrouver sur le banc des accu[...]
texte imprimÃĐ
Patricia Cornwell, Auteur ; HÃĐlÃĻne Narbonne, Traducteur | Paris : Librairie gÃĐnÃĐrale française | Le livre de poche | 1999Des cadavres, Kay Scarpetta en a vu beaucoup dans sa carriÃĻre de mÃĐdecin lÃĐgiste. Souvent dÃĐmembrÃĐs, dÃĐcoupÃĐs, ÃĐtranglÃĐs' Mais elle n'en avait pas encore vu dont la peau prÃĐsente, comme signe distinctif, les symptÃīmes de la mÊme maladie. Une mal[...]
texte imprimÃĐ
Patricia Cornwell, Auteur ; HÃĐlÃĻne Narbonne, Traducteur | Paris : Librairie gÃĐnÃĐrale française | Le livre de poche | 1997Autres annÃĐes disponibles : 1999, 2001 et 2002. Couverture de Sohiez. Traduction de H. Narbonne.
texte imprimÃĐ
Patricia Cornwell, Auteur ; HÃĐlÃĻne Narbonne, Traducteur | Paris : Calmann-LÃĐvy | Calmann-LÃĐvy crime | 1996May Scarpetta, sa niÃĻce Lucy et le policier Pete Marino se trouvent confrontÃĐs à des fanatiques qui menacent la paix mondiale... Un suspense à l'intensitÃĐ digne de la reine du crime, qui mÊle enquÊte policiÃĻre traditionnelle, technologie de poin[...]




